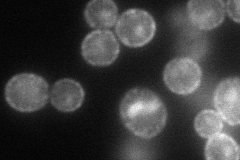
YDR384C
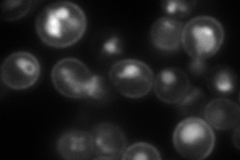
YDR384C
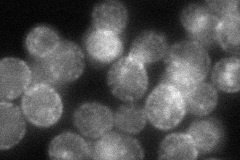
YDR384C

View description
Plasma membrane protein, regulation pattern suggests a possible role in export of ammonia from the cell; phosphorylated in mitochondria; member of the TC 9.B.33 YaaH family of putative transporters
Localization:
Intensity:
Fold change:
Significance:
-
C’ GFP library in SD

below threshold16.45 -
N' NOP1pr-GFP in SD
cell periphery,punctate88.031 -
N' TEF2pr-mCherry in SD
cell periphery,vacuole173.37 -
N' NATIVEpr-GFP in SD
cell periphery,punctate66.1619 -
N' TEF2pr-VC and Cyto-VN in SD

below threshold29.2475 -
C’ GFP library in SD+DTT

cytosol18.241.1No -
C’ GFP library in SD+H2O2

cytosol15.120.91No -
C’ GFP library in Starvation Media

cytosol14.580.88No -
C’ GFP library on the background of Pup2-DaMP

below threshold -
C’ GFP library on the background of CCT mutant

below threshold18.66231.13423No
